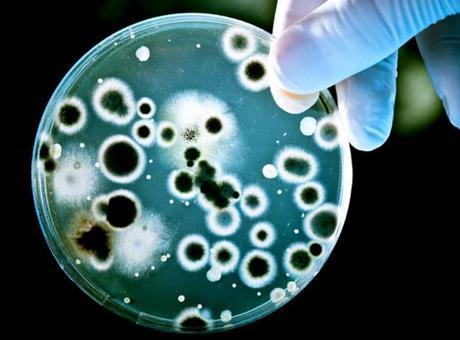

|
 |
| | #1 |
| Çevrimiçi    | Okuldan eve mikrop hatt? Didem Seymen / Haber Merkezi - Sonbaharla birlikte okullarda yay?lan hastal?klar, özellikle de üst solunum yolu enfeksiyonlar?, çocuklar arac?l???yla eve ta??narak aile bireylerini etkileyebiliyor. Evdeki ya?l?lar, kronik hastal??? olanlar ve ba????kl??? zay?f ki?iler için bu durum risk olu?turuyor. Enfeksiyon Hastal?klar? Uzman? Prof. Dr. Nafiz Koçak, enfeksiyon zincirinin, mikroorganizmalar?n bir kaynaktan ç?k?p, bula? yolu üzerinden ki?iye ula?mas?yla olu?tu?unu belirtti. Koçak, "Bu zincirin herhangi bir halkas?nda kesinti olu?turabilirsek, hastal?klar?n yay?lmas?n? engelleyebiliriz. Kayna?? kurutmak, bula? yollar?n? kesmek, ç?k?? ve giri? kap?lar?n? engellemek ve a??larla duyarl? ki?ileri azaltmak bu zincirin k?r?lmas?nda kritik rol oynar" dedi. Didem Seymen / Haber Merkezi - Sonbaharla birlikte okullarda yay?lan hastal?klar, özellikle de üst solunum yolu enfeksiyonlar?, çocuklar arac?l???yla eve ta??narak aile bireylerini etkileyebiliyor. Evdeki ya?l?lar, kronik hastal??? olanlar ve ba????kl??? zay?f ki?iler için bu durum risk olu?turuyor. Enfeksiyon Hastal?klar? Uzman? Prof. Dr. Nafiz Koçak, enfeksiyon zincirinin, mikroorganizmalar?n bir kaynaktan ç?k?p, bula? yolu üzerinden ki?iye ula?mas?yla olu?tu?unu belirtti. Koçak, "Bu zincirin herhangi bir halkas?nda kesinti olu?turabilirsek, hastal?klar?n yay?lmas?n? engelleyebiliriz. Kayna?? kurutmak, bula? yollar?n? kesmek, ç?k?? ve giri? kap?lar?n? engellemek ve a??larla duyarl? ki?ileri azaltmak bu zincirin k?r?lmas?nda kritik rol oynar" dedi.'Hastaysa dinlensin' ?ç Hastal?klar? Uzman? Dr. Canan Ku? Saydam ise ?unlar? söyledi: "Okullarda enfeksiyonlar?n h?zla yay?lmas? s?k rastlanan bir durum ve bu hastal?klar ço?unlukla eve ta??n?yor. Özellikle 65 ya? üstü büyükler, kronik hastal??? olanlar veya ba????kl??? zay?f bireyler için risk daha da büyük. Ebeveynler, çocuklarda hastal?k belirtileri görüldü?ünde onlar? dinlendirmeli ve evde kalmalar?n? sa?lamal?. Bu a?amada günlük basit önlemler de etkili: S?k el y?kamak, oyuncak ve ortak kullan?m alanlar?n?n düzenli dezenfeksiyonu, havaland?rma ve çocuklara öksürük, hap??r?k s?ras?nda do?ru davran??lar? ö?retmek bula? riskini azalt?yor. Ayr?ca tüm ailenin a?? takvimlerini güncel tutmas?, grip ve benzeri enfeksiyonlara kar?? koruyucu bir önlem olarak büyük önem ta??yor." Önleme formülü: A?? ve temizlik Prof. Dr. Nafiz Koçak: "Okullarda çocuklar aras?nda h?zla yay?lan mikroorganizmalar, solunum yoluyla ya da kap? kollar? gibi yüzeylerden al?narak eve ta??nabiliyor. Çocuklar eve geldiklerinde öksürük, hap??r?k, yüksek sesle konu?ma ya da elleriyle temas ettikleri yüzeyler arac?l???yla bu mikroplar? aile bireylerine bula?t?rabiliyor. Eve gelir gelmez ellerin y?kanmas? en ucuz ve en etkili korunma yöntemidir. Hastal?k belirtileri görülen çocuklar?n dinlenmesi, ya?l? bireylerden ayr? odada tutulmas?, evin havaland?r?lmas? ve yüzeylerin düzenli dezenfeksiyonu da enfeksiyon zincirinin k?r?lmas?nda çok önemlidir. A?? uygulamalar?n?n güncel tutulmas? da koruyucu hekimli?in temel ?art?d?r." 'Ba????kl??? güçlendirin' Dr. Canan Ku? Saydam: "Evdeki bireyleri koruman?n bir yolu da risk grubundaki ki?ilerin ba????kl?k sistemini desteklemektir. Sa?l?kl? beslenme, uyku, fiziksel aktivite ve stres yönetimi, enfeksiyonlara kar?? direnci art?r?yor. Ayr?ca vitamin ve mineral de?erlerinin düzenli kontrolü, eksiklerin takviye edilmesini sa?l?yor ve ba????kl?k sisteminin güçlenmesine katk?da bulunuyor. Herkesin sa?l?k kontrollerini takip etmesi, olas? hastal?klar?n erken dönemde fark edilmesini sa?l?yor ve bula? riskini azalt?yor. Basit önlemler, enfeksiyon zincirini k?rmada büyük fark yarat?yor." Kaynak ; Milliyet |
 |
 |
| |